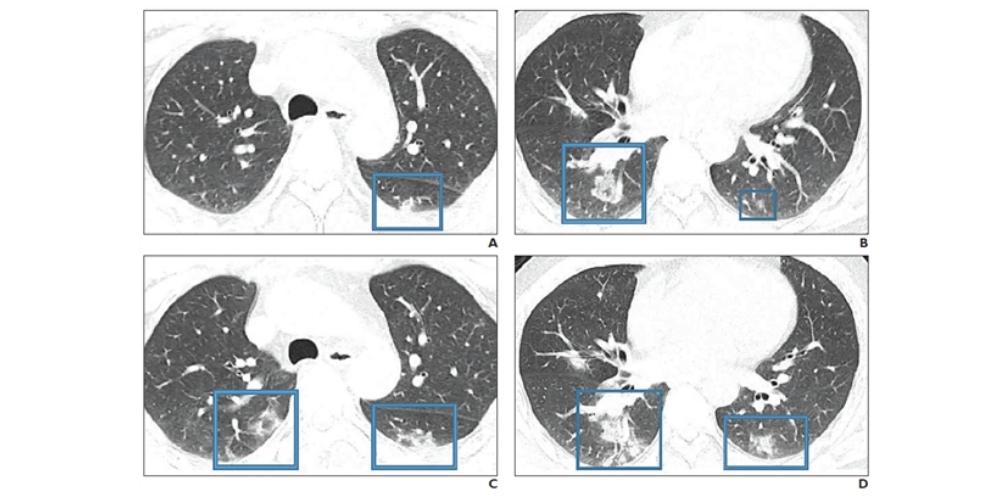
Medical imaging showing lungs infected with novel coronavirus 2019 (COVID-19)

Numerous medical experts have noted how the novel coronavirus shares imaging features with severe acute respiratory syndrome (SARS) and Middle East respiratory syndrome (MERS). However, differences evidenced in imaging exams were found in a recent study published in the American Journal of Roentgenology on February 28th. One of the most significant differences being the way in which COVID-19 tends to appear in both lungs rather than one, the study notes.
The new findings present an opportunity for clinicians to better understand and diagnose the disease. “Although the imaging features
The related MERS and SARS are also coronaviruses. Identified in 2003, SARS infected 8,422 patients and killed 916. The researchers noted that SARS has since then been contained. MERS was first identified in 2012 and has infected 2,492 patients and killed 858. New cases of MERS have persisted with the most recent one having occurred in December 2019.
"Radiologists should be prepared for the incidence of COVID-19 to escalate"
Since the outbreak of COVID-19 last December, more than 79,000 people have been infected on a global scale. According to Dr. Hosseiny and her colleagues, more than 2,600 deaths from the virus have been recorded as of February 24th.
All three diseases share comparable symptoms: fever, dyspnea, malaise, myalgia, and headache. In medical imaging, the three coronaviruses share similarities, such as ground-glass opacity, consolidation, or both. Meanwhile, lymphadenopathy is not commonly seen. Clinicians have been diagnosing COVID-19 in patients with symptoms such as these who recently traveled to China.
“An investigation of initial chest CT findings in 21 individuals with confirmed COVID-19 reported abnormal findings in 86% of patients, with a majority having bilateral lung involvement,” the authors wrote.
Moreover, in addition to the bilateral lung involvement factor, the three viruses also differ in the features that indicate a poor prognosis, according to Dr. Hosseiny’s research group:
- SARS: Bilateral (like acute respiratory distress syndrome), four or more lung zones, progressive involvement after 12 days
- MERS: Greater involvement of the lungs, pleural effusion, pneumothorax
- COVID-19: Consolidation (versus ground-glass opacity)
“Radiologists should be prepared for the incidence of COVID-19 to escalate,” the researchers wrote. “Because the etiologic and clinical features of the syndrome are similar to those of SARS and MERS, the experience from those pulmonary syndromes can be helpful for managing the emerging COVID-19 outbreak.”
Regarding recovery, Dr. Hosseiny and her colleagues recommend that patients recovering from COVID-19 be tracked with CT to assess for long-term or permanent lung damage, including fibrosis, as is seen in MERS and SARS infections.
“The experiences with SARS and MERS show that follow-up imaging should be performed in individuals recovering from COVID-19 to look for evidence of chronic involvement of the lungs (i.e., interlobular thickening, air trapping, or fibrosis)," the authors concluded.
EDM Medical Solutions offers a wide variety of hygiene products designed to protect patients and medical staff. The Parker disinfectant spray we provide can be used against novel coronavirus 2019 (COVID-19). For ultrasound equipment disinfection, we recommend the SONO ultrasound wipes. Click here to see our full collection of hygiene and disinfection products.
Learn about how radiologists are distinguishing between pneumonia caused by COVID-19 and other viruses here.